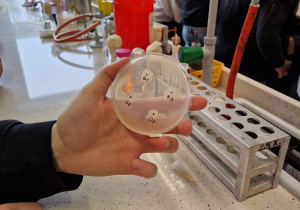
Preparaty biologiczne

Zajęcia na Wydziale Biologii UŁ
8 kwietnia 2026 uczniowie ZS Nr 1 w ramach szkolnej Innowacji Pedagogicznej "STYL ŻYCIA Z WYBORU" uczestniczyli w warsztatach eksperymentalnych w sali dydaktycznej Instytutu Mikrobiologii, Biotechnologii i Immunologii Uniwersytetu Łódzkiego. Zajęcia „Drobnoustroje jako producenci enzymów” miały charakter praktyczny i były prowadzone pod opieką pracowników naukowych, którzy wprowadzali uczestników w podstawy pracy laboratoryjnej oraz czuwali nad prawidłowym przebiegiem eksperymentów.
Podczas warsztatów uczniowie mieli dostęp do profesjonalnego sprzętu oraz materiałów dydaktycznych, co pozwoliło im samodzielnie przeprowadzać doświadczenia. Jednym z głównych elementów zajęć było przygotowywanie preparatów mikroskopowych z hodowli mikroorganizmów. Uczestnicy uczyli się, jak poprawnie nanosić próbki, barwić je oraz przygotowywać do obserwacji.
Kolejnym etapem była praca z mikroskopem. Uczniowie obserwowali przygotowane przez siebie preparaty, poznając budowę i różnorodność mikroorganizmów. Dzięki temu mogli bezpośrednio zobaczyć efekty swojej pracy oraz lepiej zrozumieć omawiane zagadnienia. Istotnym elementem warsztatów było także przeprowadzenie eksperymentu sprawdzającego, czy drożdże produkują enzym katalazę. Uczniowie samodzielnie wykonywali doświadczenie, obserwując reakcję po dodaniu odpowiednich substancji i wyciągając wnioski na podstawie uzyskanych wyników.
Warsztaty stanowiły cenne doświadczenie edukacyjne, rozwijające umiejętności praktyczne, pracę zespołową oraz zainteresowanie naukami biologicznymi
Prowadzenie warsztatów:
Mgr Aleksandra Tończyk
Mgr Marta Pietrzak
Dr Anna Jasińska
Kolejne zajęcia eksperymentalne pod hasłem „Niewidzialny mikroświat w twoich rękach” miały charakter interaktywny i wprowadzały uczestników w fascynujący świat mikroorganizmów, które na co dzień są niewidoczne, ale odgrywają ogromną rolę w życiu człowieka. Na początku omówiono różnicę między „dobrymi” a „złymi” bakteriami. Uczniowie dowiedzieli się, że nie wszystkie bakterie są groźne — wiele z nich tworzy naturalną mikrobiotę człowieka, wspierając trawienie, odporność i ogólne funkcjonowanie organizmu. Podkreślono, że ciało człowieka jest środowiskiem dla miliardów mikroorganizmów, a ich łączna masa może wynosić około 1–2 kilogramów.
Uczestnicy obserwowali pod mikroskopem bakterie pochodzące z różnych obszarów organizmu człowieka, co pozwoliło im zauważyć różnice w ich kształtach i sposobach organizacji. Szczególnie angażującą częścią warsztatów było samodzielne wykonywanie posiewów. Uczniowie pobierali próbki bakterii z różnych źródeł, takich jak skóra dłoni, telefony, banknoty
i nanosili je na szalki Petriego z pożywką. Dzięki temu mogli zobaczyć na przesłanych zdjęciach, jak różnorodne mikroorganizmy znajdują się na co dzień na ich ciele
i otoczeniu. Jednym z ciekawszych obserwacji był tzw. „bakteryjny odcisk dłoni” na pożywce czyli pojawienie się kolonii bakterii, co stanowiło wyraźny dowód na obecność mikroorganizmów na skórze. Całość warsztatów rozwijała świadomość mikrobiologiczną, uczyła zasad higieny oraz pokazywała, jak ważną rolę odgrywa niewidzialny mikroświat w życiu człowieka
Warsztaty prowadzili pracownicy naukowi:
Dr Marcin Włodarczyk z Katedry Immunologii i Biologii Infekcyjnej
Dr Agnieszka Matusiak też z Katedry Immunologii i Biologii Infekcyjnej
Dr Małgorzata Siwińska z Katedry Biologii Bakterii
Serdecznie dziękujemy Państwu Prowadzącym za możliwość uczestniczenia
w bardzo ciekawych dla nas zajęciach. Uczniowie i nauczyciele ZS Nr 1: Jadwiga Pawlicka, Dorota Majchrzak-Kapusta